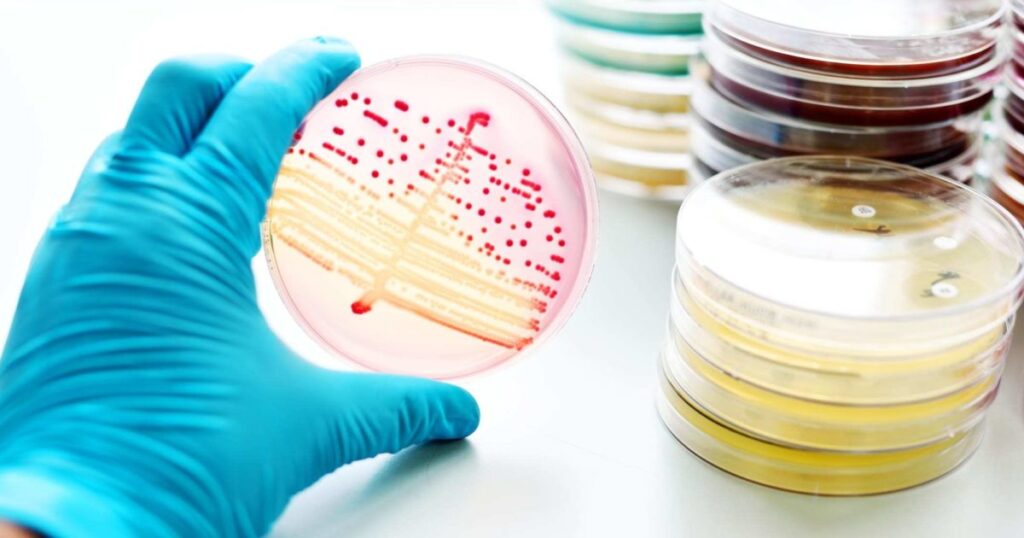
Antimicrobial Additives Market

As per Future Market Insights (FMI), the global antimicrobial additives market value is projected to increase from US$ 9,615.5 million in 2023 to US$ 20,809.5 million by 2033. Over the next ten years, global sales of antimicrobial additives are likely to thrive at 8.0% CAGR.
Increasing consumption of antimicrobial additives in food and beverage sector is a key factor driving the global market. Subsequently, rising adoption of antimicrobial-protected products for reducing the risk of infections and improving safety will boost the market.
Antimicrobial additives have become essential solutions for inhibiting growth of microbes. They extend the shelf life of products and reduce the risk of disease spread. As a result, they are being increasingly used in consumer products such as clothing, packed food items, etc.
Request Your Sample Report Now! https://www.futuremarketinsights.com/reports/sample/rep-gb-94
Growing usage across sectors such as healthcare, food & beverages, automotive, electronics, etc. is expected to fuel antimicrobial demand during the assessment period.
Antimicrobial additives find application in the healthcare sector to create a sterile environment in hospitals. They are used in numerous medical products including ventilators, examination tables, and hospital beds to reduce the spread of infections.
Rising demand for medical devices containing antimicrobial substances will bolster sales in the global market through 2033.
Regionally, North America remains the leading consumer of antimicrobial additives owing to the high demand for safe consumer items and rising awareness & consumer preference for antimicrobial products.
Prominent manufacturers of antimicrobial additives are focusing on expanding their customer based and footprints by acquired local players and launching new innovative products. They are investing rigorously in research and development to meet the regulatory standards and find newer applications for the same.
Key Takeaways from the Antimicrobial Additives Market Report:
- The global market of antimicrobial additives is projected to expand at 0% CAGR between 2023 and 2033.
- By product type, the inorganic segment is expected to remain a prominent segment accounting for over 60% of the overall market.
- By application, hygiene chemicals segment is expected to account for around one-fourth of the global antimicrobial additives consumption.
- The United States antimicrobial additives market is poised to thrive at 4% CAGR through 2033.
- Antimicrobial additive demand in China is forecast to increase at 6% CAGR from 2023 to 2033.
“The market for antimicrobial additives has the potential for significant growth because there is an increasing demand for products that are capable of self-cleaning and can prevent the spread of harmful microorganisms. This in turn will create a plethora of opportunities for antimicrobial additive manufacturers.” – says a lead analyst at FMI
Competitive Landscape
The global antimicrobial additives market is moderately consolidated with key players holding around 33% to 38% of the market share.
Key players are certainly focusing on expanding their production capacity to increase their market presence all over the globe and to gain maximum traction in the market. They are also investing significantly in acquisitions to curb their competition. For instance,
- In 2022, to strengthen its antimicrobial additives portfolio, Polygiene acquired the SteriTouch business of Radical Materials.
Ready to elevate your business? Buy the report now and unlock opportunities for exponential growth: https://www.futuremarketinsights.com/checkout/94
Antimicrobial Additives Market Top Key Players
- BASF SE
- Solvay S.A.
- Ecolab Inc.
- Lanxess AG
- Clariant AG
- Evonik Industries AG
- Huntsmann Corporation
- DuPont de Nemours, Inc.
- Ashland Inc.
- Aviant Corporation
- Sanitized AG
- Croda International Plc.
More Insights into the Antimicrobial Additives Market Report
In its latest report, Future Market Insights (FMI) offers an unbiased analysis of the global antimicrobial additives industry, providing historical data from 2018 to 2022 and forecast statistics for the period 2023 to 2033. To understand the global market potential, growth, and scope, the market is segmented based on product type, application, and region.
About Future Market Insights (FMI)
Future Market Insights, Inc. (ESOMAR certified, recipient of the Stevie Award, and a member of the Greater New York Chamber of Commerce) offers profound insights into the driving factors that are boosting demand in the market. FMI stands as the leading global provider of market intelligence, advisory services, consulting, and events for the Packaging, Food and Beverage, Consumer Technology, Healthcare, Industrial, and Chemicals markets. With a vast team of ~400 analysts worldwide, FMI provides global, regional, and local expertise on diverse domains and industry trends across more than 110 countries.
Contact Us:
Future Market Insights Inc.
Christiana Corporate, 200 Continental Drive,
Suite 401, Newark, Delaware – 19713, USA
T: +1-845-579-5705
For Sales Enquiries: sales@futuremarketinsights.com
Website: https://www.futuremarketinsights.com
LinkedIn| Twitter| Blogs | YouTube